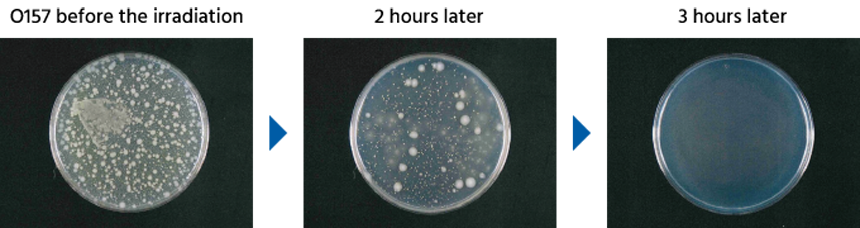

It has been proved that the active elements produced by Streamer technology decomposes and neutralizes O157 by contacting O157, which causes food poisoning. Furthermore, this time, it has been proved that the suppression effect is increased 18 times by operating two Streamer units.
- This is the demonstration result using a streamer discharge device for testing.
- The effect of products equipped with Streamer technology or the effect in actual use environment may differ.
Demonstration of the suppression effect against O157
Operation of one Streamer unit
Operation of two Streamer units


The survival rate of O157 after 2 hours of the Streamer irradiation was 0.1% for two units operation compared to 1.8% for one unit operation, confirming that the suppression effect was 18 times. In addition, after 3 hours, it was confirmed that the suppression effect was 99.9% for both one-unit operation and two-unit operation.
- This is the demonstration result using a streamer discharge device for testing.
- The effect of products equipped with Streamer technology or the effect in actual use environment may differ.
Testing organization
Japan Food Research Laboratories
Test method
By irradiating the O157 with Streamer for 1, 2, 3, 4, 8 hours and inoculating the cultured cells, we observed the residual state of the O157 by the difference in the Streamer irradiation time.
O157 with strong toxin and infectivity

O157 produces a strong toxin called Verotoxin, which causes abdominal pain, hemorrhagic diarrhea, and vomiting. It is one of the very dangerous bacteria that can cause severe symptoms and deaths when infected in infants and the elderly. In addition, infectiousness is strong. General food poisoning does not develop unless "about 1 million" of bacteria invade, whereas O157 develops food poisoning even with a small number of "about 100" bacteria.